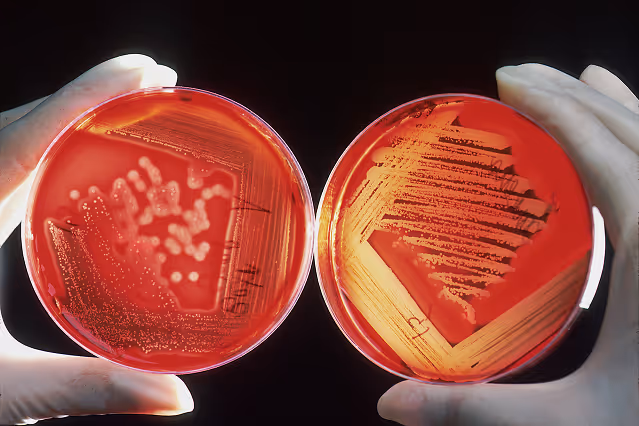

Research & Findings
Since 2011, Halcyon has studied the GASP-1 cancer biomarker, using our findings to expand our understanding of protein biomarkers more broadly to neurodegenerative conditions as well.
Below is a sample of our GASP-1 publications.
Below is a sample of our GASP-1 publications.

Progression in Benign Prostatic Hyperplasia
We confirmed a 5-fold difference in serum GASP-1 levels between BPH and PCa validated through GASP-1 IHC.

A Valid Thyroid Cancer Biomarker
We found that GASP-1 was significantly overexpressed in early-stage malignant thyroid neoplasms.

Proliferation of Triple Negative Breast Cancer
The novel protein GASP-1 appears to be a universal cancer marker predictive of cancer severity.

A Cancer Invasion and Progression Biomarker
We confirmed GASP-1 granules of all sizes are involved in cancer invasion and progression.

A Ubiquitous Cancer Biomarker
We found that sera from patients with brain, liver, breast and lung cancers expressed 4–7 fold more GASP-1.
A Potential Breast Cancer Biomarker
We identified serum biomarkers associated with early and advanced stages of breast cancer.